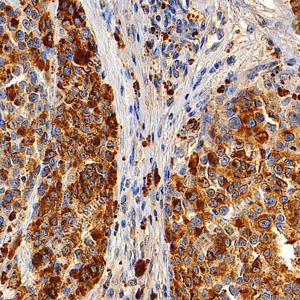

Recombinant Anti-Melanoma gp100 antibody (Mouse mAb)
- 50 μL
产品信息
蛋白质全称 | 黑素细胞蛋白PMEL |
别名 | 95 kDa melanocyte specific secreted glycoprotein, 95 kDa melanocyte-specific secreted glycoprotein, D12S53E, gp100, M-beta, ME20, ME20 M/ME20 S, ME20-M, ME20-S, ME20M, ME20M/ME20S, ME20S, Melanocyte lineage specific antigen GP100, Melanocyte protein mel 17, Melanocyte protein Pmel 17, Melanocyte protein Pmel 17 precursor, Melanocytes lineage-specific antigen GP100, Melanoma associated ME20 antigen, Melanoma gp100, Melanoma-associated ME20 antigen, Melanosomal matrix protein 17, Melanosomal matrix protein17, P1, p100, p26, PMEL 17, PMEL, Premelanosome protein, Secreted melanoma-associated ME20 antigen, SI, SIL, D12S53E, PMEL17, SILV, PMEL |
Uniprot ID | P40967 |
免疫原 | 人Melanoma gp100重组蛋白 |
抗体亚型 | IgG1 |
克隆号 | SB580 |
纯化方式 | 亲和纯化 |
亚细胞定位 | 黑色素体, 细胞质 |
应用
| 应用 | 物种 | 稀释 | 阳性样品 |
| IHC/IF 免疫组织化学/免疫荧光 | 人 | 1: 500-1: 1500 | 黑色素瘤 |
背景
Forms physiological amyloids that play a central role in melanosome morphogenesis and pigmentation. The maturation of unpigmented premelanosomes from stage I to II is marked by assembly of processed amyloidogenic fragments into parallel fibrillar sheets, which elongate the vesicle into a striated ellipsoidal shape. In pigmented stage III and IV melanosomes, the amyloid matrix serves as a platform where eumelanin precursors accumulate at high local concentrations for pigment formation. May prevent pigmentation-associated toxicity by sequestering toxic reaction intermediates of eumelanin biosynthesis pathway.
图像
| IHC检测Melanoma gp100蛋白(货号 GB150160). 样品: 人黑色素瘤, 4%多聚甲醛 (货号G1101) 固定12-24小时. 抗原修复: 抗原修复仪 (货号 ARI-4),Tris-EDTA抗原修复液(pH 9.0) (货号G1203), 水浴100℃, 25分钟. —抗: 1: 1000稀释, 4℃ 孵育过夜. 二抗: S-vision免疫组化多聚二抗(山羊抗小鼠), 即用型(货号G1301), 室温孵育20分钟. |
| IHC检测Melanoma gp100蛋白(货号 GB150160). 样品: 人黑色素瘤, 4%多聚甲醛 (货号G1101) 固定12-24小时. 抗原修复: 抗原修复仪 (货号 ARI-4),Tris-EDTA抗原修复液(pH 9.0) (货号G1203), 水浴100℃, 25分钟. —抗: 1: 1000稀释, 4℃ 孵育过夜. 二抗: S-vision免疫组化多聚二抗(山羊抗小鼠), 即用型(货号G1301), 室温孵育20分钟. |
| IHC检测Melanoma gp100蛋白(货号 GB150160). 样品: 人黑色素瘤, 4%多聚甲醛 (货号G1101) 固定12-24小时. 抗原修复: 抗原修复仪 (货号 ARI-4),Tris-EDTA抗原修复液(pH 9.0) (货号G1203), 水浴100℃, 25分钟. —抗: 1: 1000稀释, 4℃ 孵育过夜. 二抗: S-vision免疫组化多聚二抗(山羊抗小鼠), 即用型(货号G1301), 室温孵育20分钟. |
储存
| 储存条件 | 在-20℃下储存一年, 避免反复冻融. |
| 储存缓冲液 | 含0.15% ProClin300防腐剂, 100 μg/mL牛血清白蛋白和50%甘油的磷酸盐缓冲液. |
注意:
1.本产品仅供研究使用.
2.建议用一抗稀释液(G2025)稀释本产品.
| 货号 | 名称 | 规格 | 价格 | 操作 |
|---|
| 货号 | 名称 | 规格 | 价格 | 操作 |
|---|